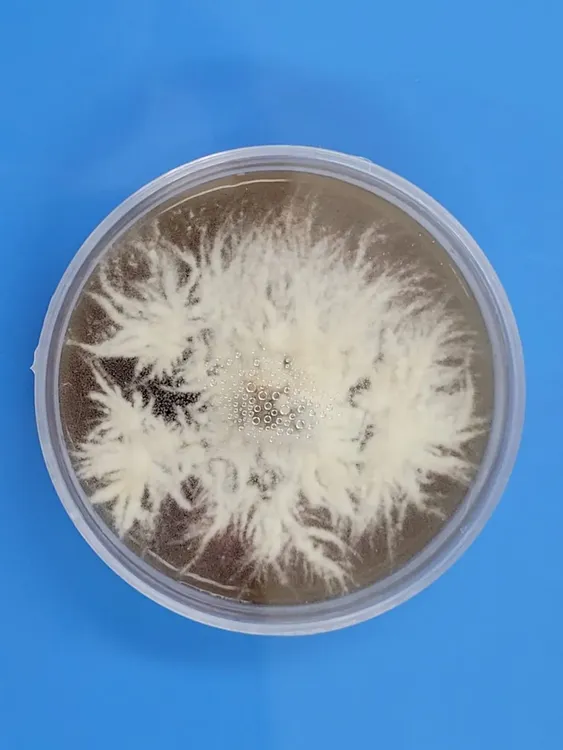
cultivo axénico de hericium erinaceous_melena de león_1718797239
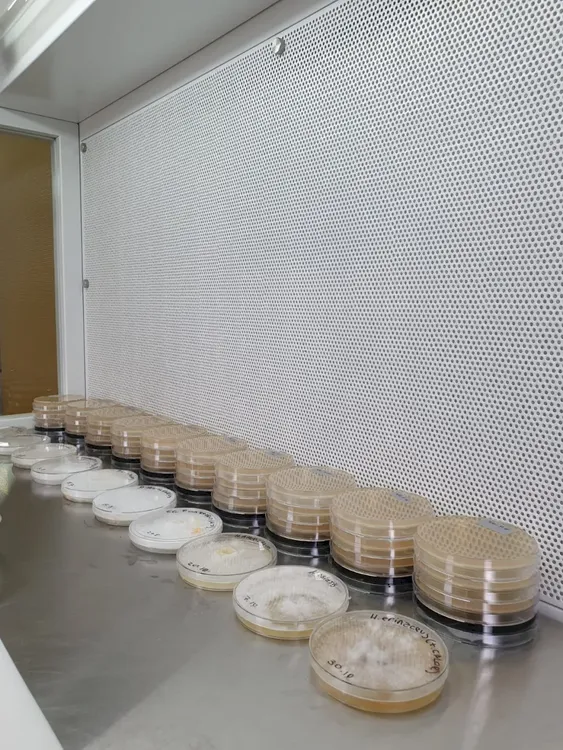
repiques de cultivos de hbcc_1718797172

La UNTDF lanza la provisión local de insumos biológicos para la producción de hongos comestibles
ecovida ambienteLa Universidad Nacional de Tierra del Fuego AIAS, a través del laboratorio del Instituto de Ciencias Polares, Ambiente y Recursos Naturales (ICPA) ofrece un nuevo servicio para el desarrollo productivo de la provincia: la producción de micelio madre y cultivos puros de hongos basidiomicetos comestibles y cultivables (HBCC).
El proyecto “Fortalecimiento de las capacidades del cepario de hongos basidiomicetos de la UNTDF, como eslabón primordial de la cadena productiva fueguina de hongos comestibles (HC)”, presentado por la Secretaría de Desarrollo Productivo y PyME del Ministerio de Producción y Ambiente provincial y financiado por el Consejo Federal de Inversiones, busca satisfacer la necesidad de abastecer con micelio madre y cultivos puros a la producción local de hongos comestibles.
El laboratorio del ICPA, por intermedio del trabajo de la Dra. Noelia Paredes, mantiene una colección de 19 especies de hongos, que se facilitan para el estudio y el desarrollo de procesos de investigación, docencia y transferencia. Como resultados del mencionado proyecto se consolidó y organizó el cepario de hongos, posicionando a la UNTDF como un proveedor especializado local de micelio y cultivos fúngicos.
La directora del Instituto de Ciencias Polares, Ambiente y Recursos Naturales, Dra. Alicia Moretto, confirma que “ya se realizó el primer aprovisionamiento de cultivos puros de las especies Pleurotus ostreatus y Ganoderma lucidum a un productor local de hongos comestibles, y esperamos poder llegar a más productores tanto comerciales como familiares para de este modo aportar a la mejora de la calidad de la oferta de alimentos para quienes habitamos este territorio”.
Próximamente se publicará el procedimiento para solicitar la compra y/o adquisición de los productos biológicos. Para solicitar mayor información sobre los servicios, comunicarse a la dirección [email protected]
Fuente: Prensa UNTDF


La UNTDF presenta el webdoc Casa Moneta: Primer hogar argentino en la Antártida

Alerta por el "Súper RIGI": organizaciones advierten sobre riesgos ambientales, soberanía digital y falta de regulación para la inteligencia artificial

Pumas en Santa Cruz: Entre el Conflicto Ganadero y la Coexistencia Posible

Alerta por fuente radiactiva robada en Rosario: advierten que el cesio 137 sigue siendo un riesgo para la salud y el ambiente